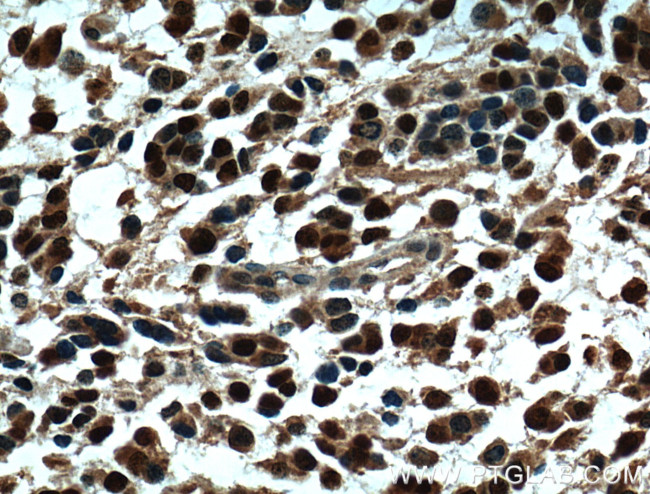
OLIG2 Antibody in Immunohistochemistry (Paraffin) (IHC (P))

Search
Proteintech
OLIG2 Polyclonal Antibody
{{$productOrderCtrl.translations['antibody.pdp.commerceCard.promotion.promotions']}}
{{$productOrderCtrl.translations['antibody.pdp.commerceCard.promotion.viewpromo']}}
{{$productOrderCtrl.translations['antibody.pdp.commerceCard.promotion.promocode']}}: {{promo.promoCode}} {{promo.promoTitle}} {{promo.promoDescription}}. {{$productOrderCtrl.translations['antibody.pdp.commerceCard.promotion.learnmore']}}
产品信息
13999-1-AP
种属反应
已发表种属
宿主/亚型
分类
类型
抗原
偶联物
形式
浓度
规格
纯化类型
保存液
内含物
保存条件
运输条件
产品详细信息
Immunogen sequence: MDSDASLVS SRPSSPEPDD LFLPARSKGS SGSAFTGGTV SSSTPSDCPP ELSAELRGAM GSAGAHPGDK LGGSGFKSSS SSTSSSTSSA AASSTKKDKK QMTEPELQQL RLKINSRERK RMHDLNIAMD GLREVMPYAH GPSVRKLSKI TTLLLARNYI LMLTNSLEEM KRLVSEIYGG HHAGFHPSAC GGLAHSAPLP AATAHPAAAA HAAHHPAVHH PILPPAAAAA AAAAAAAAVS SASLPGSGLP SVGSIRPPHG LLKSPSAAAA APLGGGGGGS GASGGFQHWG GMPCPCSMCQ VPPPHHHVSA MGAGSLPRLT SDAK (1-323 aa encoded by BC047511)
靶标信息
This gene encodes a basic helix-loop-helix transcription factor which is expressed in oligodendroglial tumors of the brain. The protein is an essential regulator of ventral neuroectodermal progenitor cell fate. The gene is involved in a chromosomal translocation t(14;21)(q11.2;q22) associated with T-cell acute lymphoblastic leukemia. Its chromosomal location is within a region of chromosome 21 which has been suggested to play a role in learning deficits associated with Down syndrome. Tissue specificity: Expressed in the brain, in oligodendrocytes. Strongly expressed in oligodendrogliomas, while expression is weak to moderate in astrocytomas. Expression in glioblastomas highly variable.
仅用于科研。不用于诊断过程。未经明确授权不得转售。
生物信息学
蛋白别名: basic domain, helix-loop-helix protein, class B, 1; Basic helix loop helix protein class B1 (bHLHB1); basic helix-loop-helix protein 19 (bHLHe19); BHLHB1; bHLHe19; Class B basic helix-loop-helix protein 1; Class E basic helix-loop-helix protein 19; human protein kinase C-binding protein RACK17; olig-2; Oligo2; Oligo2 antibody; oligodendrocyte lineage transcription factor 2; Oligodendrocyte specific bHLH transcription factor 2; Oligodendrocyte transcription factor 2; oligodendrocyte-specific bHLH transcription factor 2; Protein kinase C-binding protein 2; Protein kinase C-binding protein 2 (PRKCBP2); Protein kinase C-binding protein RACK17; unnamed protein product
基因别名: AI604895; BHLHB1; BHLHE19; Olg-2; OLIG2; OLIGO2; PRKCBP2; RACK17; RK17
UniProt ID: (Human) Q13516, (Mouse) Q9EQW6
Entrez Gene ID: (Human) 10215, (Mouse) 50913, (Rat) 304103